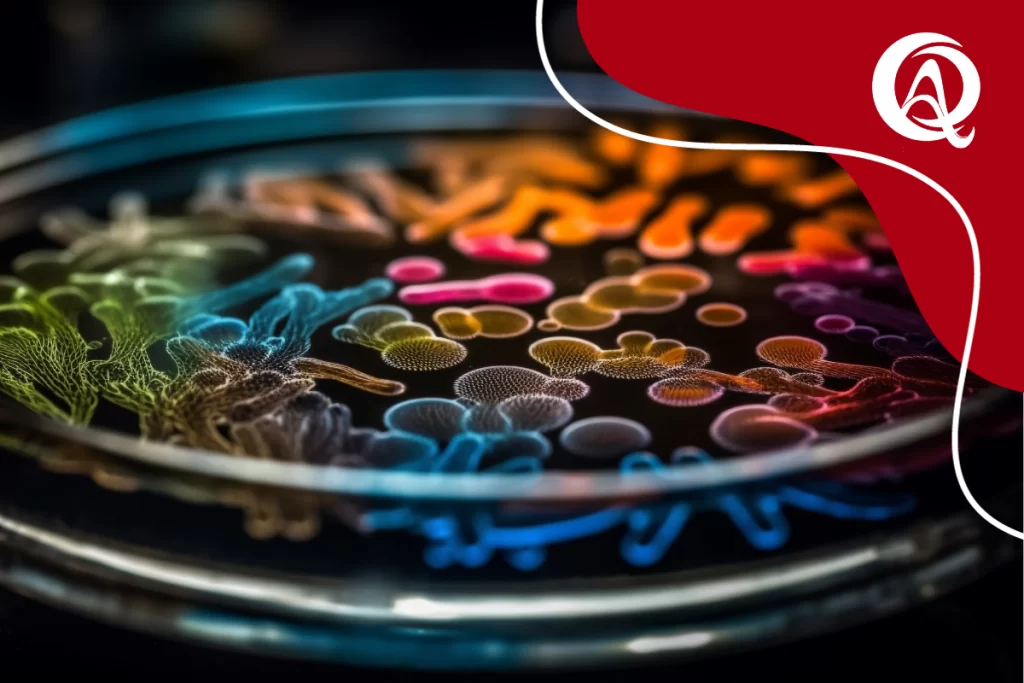

Glitter Biodegradável
Glitter Biodegradável: Brilhe com Consciência A princípio, stá chegando o Carnaval, época de alegria, festa e muito glitter! Porém, ainda devemos nos preocupar com o impacto que deixamos no mundo, o descarte incorreto das particula de glitter chegam até os oceanos, prejudicando a vida marinha. Por isso, trazemos uma alternativa: O Glitter biodegradável. Impacto do Glitter no Meio Ambiente: Dito isso, o glitter é tradicionalmente produzido por pequenas partículas de plástico, metal ou vidro que brilham por refletir a luz. Uma grande quantidade é vista durante o Carnaval, nas maquiagens e decorações festivas. Porém, uma desvantagem é o fato do glitter ser um microplástico que tem grande impacto quando seu descarte acaba nos oceanos! Além disso, o impacto do microplástico nos oceanos tem sido muito estudado nos últimos anos. Estima-se, em pesquisas recentes, que os microplásticos perturbam o equilíbrio desde o início da cadeia de alimentação aquática, afetando plânctons, ostras, mexilhões, entre outros, fato que afeta a cadeia toda. Glitter Biodegradável: Dessa mesma forma, o glitter biodegradável pode ser produzido com diversas matérias-primas, incluindo celulose, amido de milho e outros materiais naturais. Esses materiais são mais facilmente degradados por microorganismos na natureza, tornando-os uma escolha mais ecologicamente correta. Algumas das vantagens dessa substituição: Compromisso com a Sustentabilidade: Eliminando a presença prejudicial de microplásticos e minimizando o impacto ambiental. Decomposição Rápida e Segura: Projetado para se decompor rapidamente comparado ao plástico, reduzindo sua permanência no meio ambiente e protegendo a vida marinha. Variedade de Cores e Aplicações: Ainda é possível brilhar de todas as cores e sustentar a proteção da vida marinha. Conscientização Ambiental: A escolha do glitter biodegradável leva a conscientização ambiental, contribuindo para um impacto positivo na luta pelo meio ambiente. Por fim, ao considerar o uso de glitter biodegradável, os consumidores podem contribuir para a redução do impacto ambiental associado aos resíduos de plástico, ao mesmo tempo em que desfrutam de produtos brilhantes e coloridos. Brilhe com Consciência!! Quer empreender e impactar o mundo positivamente? A Catálise Jr. pode te ajudar! Nossa equipe especializada está pronta para oferecer todo o suporte necessário. Entre em contato e agende sua reunião diagnóstica gratuita para que consigamos entender melhor seu negócio!